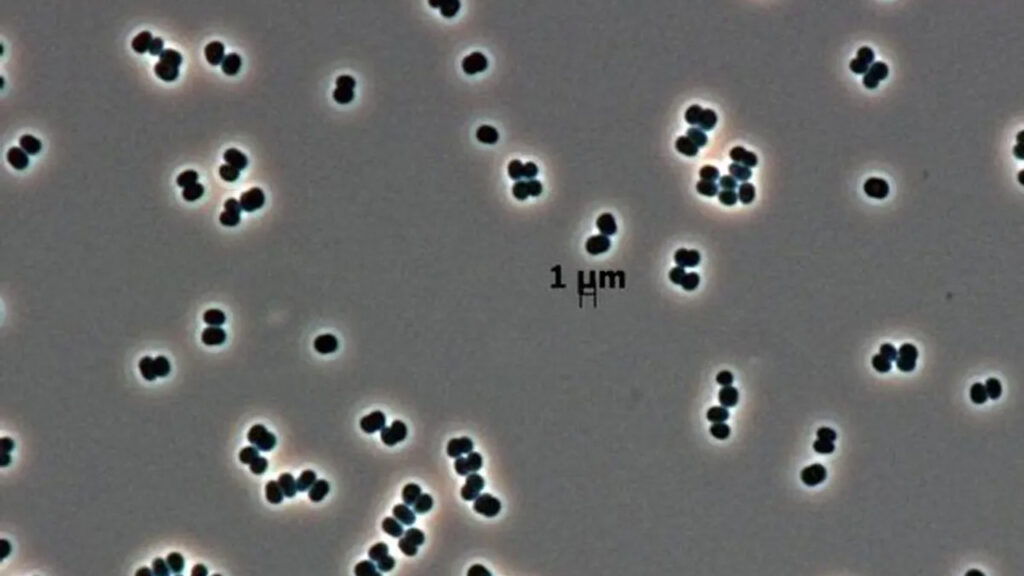

Uzay ajanslarının titiz sterilizasyonuna rağmen bir bakteri, kuruma ve besin eksikliğinde “uyku haline” geçerek hayatta kalmayı başarıyor. Tersicoccus phoenicis adlı bu ekstremofil, standart yöntemlerle tespit edilemiyor ve Mars’a yayılma riskiyle birlikte tüberküloz tedavisini de etkileyebilir. Kaynak chip
Ölü taklidi yapan süper bakteriler, uzayı bile tehdit ediyor